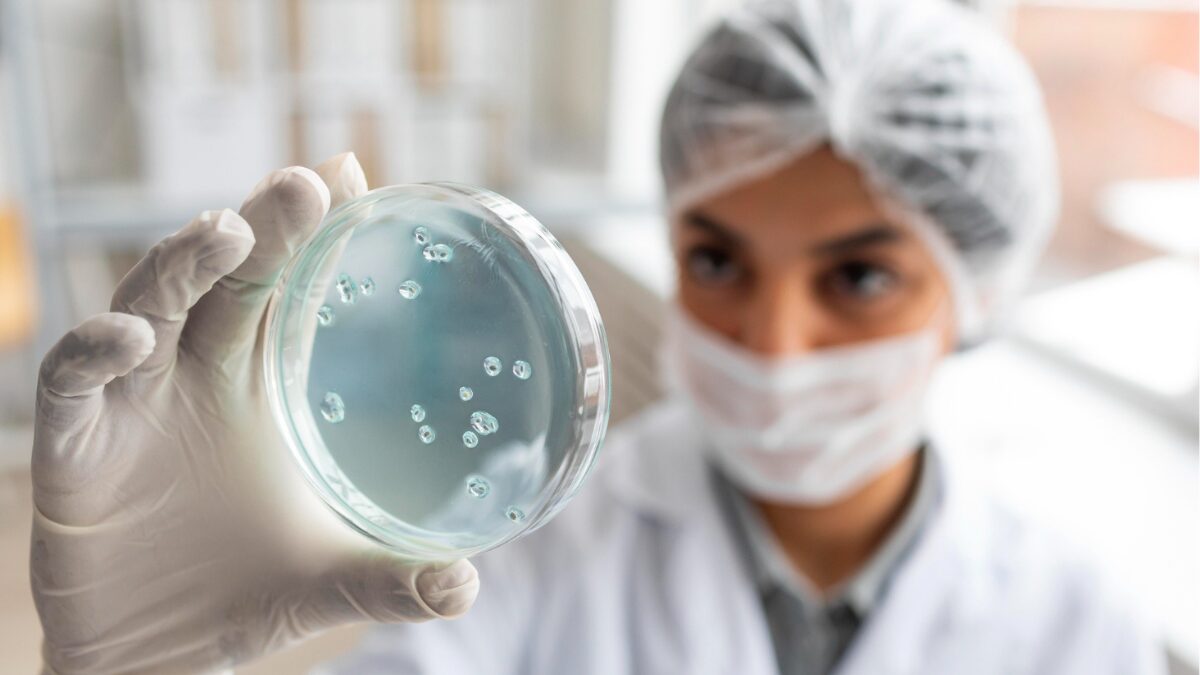

Más de un millón de muertes al año son causadas por la resistencia antimicrobiana, según la OMS
El problema surge cuando bacterias, virus, hongos o parásitos dejan de responder a los tratamientos disponibles
La resistencia a los antimicrobianos (RAM) es una de las crisis de salud más graves que enfrenta la humanidad. Según la Organización Mundial de la Salud (OMS), más de un millón de personas mueren cada año debido a infecciones que ya no responden a los antibióticos y otros medicamentos esenciales. Esta cifra, que ya es alarmante, podría aumentar rápidamente si no se toman medidas inmediatas y coordinadas. La RAM no solo afecta a la salud humana, sino que también pone en riesgo la salud animal, vegetal y el equilibrio de nuestros ecosistemas.
El problema surge cuando bacterias, virus, hongos o parásitos dejan de responder a los tratamientos disponibles. Esto significa que infecciones que antes eran controlables pueden volverse graves o incluso mortales. La propagación de patógenos resistentes aumenta la dificultad de tratar enfermedades comunes, incrementa la duración de la hospitalización y eleva los costos de atención médica. Como explica Yvan Hutin, director de resistencia antimicrobiana de la OMS, “todos los países se enfrentan a la resistencia antimicrobiana, y cuanto menor sea el acceso a prevención, diagnóstico y tratamiento, mayor será el riesgo de sufrir infecciones resistentes”.
Acción global: la clave para frenar la resistencia
La OMS ha lanzado la campaña de la Semana Mundial de Concienciación sobre la RAM bajo el lema “Actuar ahora: proteger nuestro presente, asegurar nuestro futuro”. La iniciativa busca transformar los compromisos políticos de la Reunión de Alto Nivel de las Naciones Unidas de 2024 en acciones concretas y efectivas. Esto requiere un esfuerzo coordinado de todos los sectores: personal sanitario, investigadores, agricultores, responsables ambientales y la sociedad civil. Cada acción, desde implementar protocolos de uso responsable de antibióticos hasta gestionar residuos de manera sostenible, contribuye a frenar la propagación de patógenos resistentes.
La campaña también persigue educar a la población sobre la gravedad de la RAM, promover la investigación y fomentar políticas públicas que aseguren la disponibilidad de tratamientos eficaces. La OMS enfatiza que solo mediante una cooperación global se podrá mantener la eficacia de los antimicrobianos y proteger a las futuras generaciones. Como concluye la organización: “Juntos podemos construir un mundo más sano y sostenible, preservando los avances de la medicina y evitando que décadas de progreso se pierdan frente a esta amenaza silenciosa”.
La resistencia antimicrobiana no es un problema distante; está presente en todos los rincones del planeta. Actuar con rapidez y responsabilidad es imprescindible para evitar que enfermedades comunes se conviertan en crisis mortales, recordándonos que la salud de cada individuo está intrínsecamente ligada a la acción colectiva.











